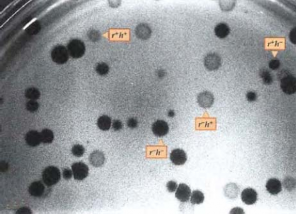
Hình 5 2 Sự xâm nhập của phage vào tế bào vật chủ theo cả 2 dạng bố mẹ 2

và bản sao còn lại ở vị trí cũ. Trong con đường bảo thủ (như ở trường hợp Tn10) không có sự sao chép. Thay vào đó, yếu tố được cắt ra từ nhiễm sắc thể hoặc plasmid và được gắn vào vị trí mới. Con đường này còn được gọi là con đường "cắt và dán" (cut and paste)
2. Các yếu tố di truyền vận động ở virus
Retrovirus là virus RNA sợi đơn, sao chép qua trung gian DNA sợi kép. RNA được sao chép thành DNA nhờ enzyme phiên mã ngược. DNA sợi kép được gắn vào nhiễm sắc thể tế bào chủ, từ đó phiên mã tạo RNA virus và tạo protein hình thành hạt virus mới. Một vài retrovirus như virus tạo khối u chuột (MMTV) và virus sarcoma Rous (RSV) xâm nhiễm kích thích tạo khối u ung thư. Khi gắn vào nhiễm sắc thể, bản sao DNA sợi kép của genome virus được gọi là provirus.
Phương thức phiên mã ngược của các phần tử di động tương tự như của retrovirus. Sự di chuyển qua trung gian RNA nhờ reverse transcritase tạo cDNA và sự xen đoạn cDNA vào vị trí mới được gọi là retrotransposition.
Retrotransposition tạo bản sao của phần tử ở vị trí mới, trong khi phân tử cho ban đầu vẫn giữ nguyên cấu trúc không đổi. Do vậy retrotransposition tạo nên một ít đứt đoạn và các tái cấu trúc của bộ gene tế bào chủ. Những biến đổi của bộ gene liên quan với retrotransposition sẽ dẫn đến việc làm ngừng hay hoạt hóa các gene mà một số gene có thể gây ung thư.
3. Các yếu tố di truyền vận động ở vi nấm
Gery Fink và cs. là những người đầu tiên sử dụng nấm men để nghiên cứu điều hoà hoạt tính gene ở eukaryote. Các tác giả này đã phân lập được hàng ngàn đột biến gene HIS4 mã hóa enzyme tham gia tổng hợp histidine. Trong số hơn 1.500 đột biến ngẫu nhiên HIS4 được tìm thấy có 2 đột biến có kiểu hình không bền vững. Các đột biến không bền vững này có tần số phục hồi lại dạng kiểu dại cao 1.000 lần hơn các đột biến HIS4 khác. Những đột biến này cho đoạn DNA lớn xen vào gene HIS4, sự xen vào này được thực hiện do một trong các yếu tố là Ty của nấm men. Có 35 bản sao của yếu tố xen đoạn gọi là Ty1 ở genome của nấm men.
Việc tạo dòng những yếu tố này từ các allele đột biến cho thấy xen đoạn này không giống với yếu tố IS hoặc transposon của vi khuẩn. Thay vào đó chúng có đặc tính của retrovirus (virus của động vật). Có sự giống nhau trong cấu trúc và thành phần gene của retrovirus và yếu tố Ty1 được phân lập từ đột biến HIS4. Giống với retrovirus, transposon của nấm men có lặp đoạn cuối dài (long terminal repeat sequence) LTRs, chứa hàng
Có thể bạn quan tâm!
-
Sự Tương Tác Giữa Yếu Tố Shine-Dalgarno Của Một Mrna Và Đoạn Trình Tự Tương Ứng Ở Đầu 3' Của Rrna 16S Có Mặt Trong Tiểu Đơn Vị Ribosome Bé -
Hậu Quả Của Đột Biến Điểm Trong Gene. Codon 1-4 Nằm Trong Vùng Mã Hóa Của Gene -
Bảo Vệ Bằng Hệ Thống Các Enzyme Methylase Và Restriction Endonuclease -
Đột Biến Mất Đoạn Được Sử Dụng Để Chia Locus Rii Của Bacteriophage T4 Thành 7 Vùng Và 47 Tiểu Vùng Nhỏ -
Các Vùng Chức Năng Của Phân Tử Rna Viroid -
Các Đường Cong Sinh Trưởng. Đồ Thị Bên Trái Cho Thấy Tốc Độ Sinh Trưởng Được Biểu Thị Bằng Các Chấm Trên Một Thang Tuyến Tính. Đồ Thị Bên
Xem toàn bộ 226 trang tài liệu này.
trăm cặp base, được gọi là trình tự nằm ở 2 phía đoạn mã hóa, cả hai đều chứa gene gag và gene pol. Retrovirus có ít nhất 3 gene mã hóa cho 3 protein trong quá trình sao chép: gene gag mã hóa cho một protein có vai trò làm biến tính RNA genome. Gene pol mã hóa enzyme reverse transcriptase. Gene env mã hóa cho protein vỏ. Yếu tố Ty chỉ chứa gene gag và gene pol, không chứa gene env (hình 4.10)
Đoạn lặp lại trực tiếp 5 bp của DNA mục tiêu
Bản sao Ty1 xen vào
Phiên mã NST khác
Dịch mãEnzyme phiên mã ngược
Phiên mã ngược
Hình 4.10 Sự chuyển vị nhờ retrotransposition
Mô hình về sự chuyển vị nhờ retrotransposon. Một bản phiên mã RNA từ retrotransposon dưới tác dụng của enzyme phiên mã ngược tạo thành DNA nhờ enzyme reverse transcriptase được mã hóa bởi retrotransposon. Bản sao DNA được chèn vào vị trí mới trên bộ gene.
Vào năm 1985, J. Bocke và G. Fink đã chứng minh, yếu tố Ty1, giống với retrovirus, thực hiện việc di chuyển qua trung gian RNA. Chúng bắt đầu bằng biến đổi yếu tố Ty1 của nấm men được tạo dòng trên plasmid. Trước tiên ở một đầu mút của yếu tố, có sự xen vào một promoter được hoạt hóa nhờ thêm galactose vào môi trường. Thứ hai, một intron từ một gene khác của nấm men được đưa vào vùng mã hóa của transposon Ty. Sự thêm vào galactose làm tăng tần số chuyển vị của yếu tố Ty bị biến đổi. Điều này làm tăng số lượng RNA, vì galactose kích thích phiên mã RNA Ty bắt đầu từ promoter nhạy cảm galactose.
Câu hỏi và Bài tập
1. Vì sao phần lớn các đột biến ảnh hưởng đến các gene cấu trúc thường là lặn so với các allele hoang dại?
2. Sự hình thành đột biến dịch khung diễn ra như thế nào?
3. Các hóa chất gây đột biến có đặc điểm gì?
4. Giải thích cơ sở đột biến của các tác nhân gây đột biến sau: 5- bromuracil, acid nitrơ và acridin.
5. Hãy mô tả một loại sai hỏng ngẫu nhiên dẫn đến đột biến.
6. Phân tích sự giống nhau và khác nhau giữa các kiểu transposition.
7. Các trình tự đảo ngược có vai trò gì trong transposition?
8. Cho một chuỗi trình tự nucleotid trên mRNA như sau: Dạng hoang dại: ... 5' AAUCCUUACGGA 3' ... Dạng đột biến: .... 5' AAUCCUACGGA 3' ...
Hãy cho biết sai hỏng trên xảy ra do loại đột biến nào?
9. Đột biến xảy ra trong trình tự nucleotid do kết cặp nhầm như sau: 5' AGCTGCCTT 3'
3' ACGATGGAA 5' (mạch khuôn)
Acid amin nào liên quan codon có nucleotid bị thay đổi như trên?
Tài liệu Tham khảo
1. Phạm Thành Hổ. 2000. Di truyền học. NXB Giáo Dục.
2. Lê Đình Lương, Phan Cự Nhân (1998). Cơ sở di truyền học. NXB GD.
3. Hoàng Trọng Phán. 1995. Di truyền học phân tử. Trung tâm Đào tạo Từ xa, Đại học Huế
4. Anthony J. F. Griffiths, Susan R. Wessler, Richard C. Lewontin, William M. Gelbart, David T. Suzuki, Jeffrey H. Miller. 2004. An introduction to genetics analysis. W.H. Freeman Publishers.
5. Harlt D.L., Jones E.W. 1998. Genetics - Principle and analysis. Jone and Bartlett Publshers, Toronto, Canada.
6. Stansfield W.D. 1991. Schaum’s outline of theory and problems of genetics. McGraw-Hill, Companies, Inc., United States of America.
7. Watson D.J, Baker T.A., Bell S.P., Gann A., Levine M., Losick R. 2004. Molecular biology of the gene. Benjamine Cummings, San Francisco, United States of America.
Chương 5
Di truyền học Virus
I. Đặc tính của các virus
1. Tính đa dạng về cấu trúc và thành phần di truyền
Virus có bộ gene rất đa dạng. Bộ máy di truyền của virus có thể là DNA mạch kép (double strand - dsDNA), DNA mạch đơn (single strand - ssDNA), RNA mạch kép (dsRNA) hay RNA mạch đơn (ssRNA). Bộ gene RNA của virus là một phân tử hoặc một đoạn, sợi đơn phân cực mạch (+) hoặc mạch (-), có thể ở dạng vòng tròn hay dạng thẳng. Virus nhỏ nhất có nhất có khoảng 4 gene, virus lớn có khoảng vài trăm gene. Bộ gene của virus cấu trúc đa dạng nhưng đều đảm bảo yêu cầu chung là phải sao chép được trong tế bào chủ tạo ra cả genome cho lắp ráp virion thế hệ sau và các mRNA phải tổng hợp protein của virus.
2. Tính đặc thù về vật chủ (Host specificity)
Mỗi kiểu virus có thể nhiễm và kí sinh chỉ ở một biên độ giới hạn của tế bào được gọi là biên độ chủ (host range). Các virus nhận biết tế bào chủ theo nguyên tắc “ống khóa và chìa khóa” các protein bên ngoài của virion lấp vừa các điểm nhận trên bề mặt tế bào. Một số virus có biên độ chủ rộng đủ để xâm nhập vào vài loài. Chẳng hạn, các virus bệnh dại có thể nhiễm nhiều loài có vú gồm gậm nhấm, chó và người. Biên độ có thể rất hẹp như nhiều phage chỉ nhiễm vi khuẩn E. coli.
II. Di truyền học thể thực khuẩn (Bacteriophage hay phage)
1. Sự hình thành vết tan và các thể đột biến phage
Phage được phát hiện dễ dàng vì trong chu trình tan, một tế bào bị nhiễm phage vỡ ra và giải phóng các hạt phage vào môi trường (hình 5.1). Sự tạo thành các đốm đã được quan sát.
Một số lớn tế bào vi khuẩn (khoảng 108 tế bào) được trãi lên trên môi trường đặc. Sau một thời gian sinh trưởng, tạo một lớp tế bào vi khuẩn màu trắng đục. Nếu phage có mặt ở thời điểm vi khuẩn được trãi lên môi trường, nó sẽ nhiễm vào tế bào vi khuẩn. Sau đó tế bào nhiễm phage bị làm tan và giải phóng nhiều phage mới. Thế hệ sau này của phage lại nhiễm vào vi khuẩn gần đó, và tham gia vào chu trình tan khác, các vi khuẩn này bị vỡ giải phóng ra nhiều phage, chúng có thể nhiễm vào các vi khuẩn khác ở vùng lân cận. Chu trình xâm nhiễm của phage được tiếp tục và sau nhiều giờ, phage phá huỷ tất cả các tế bào vi khuẩn của một
vùng, tạo đốm (plage) trong suốt khác với lớp tế bào vi khuẩn màu trắng
đục.

Tế bào không bị xâm nhiễm
Phân hủy tế bào chủ
Phage lắp ghép bên trong tế
Phage tự do
Chu trình sinh tan
Phage hấp phụ lên tế bào chủ
bào chủ Nucleic acid của phage
Vật chất di truền tế bào chủ bị phá hủy
Phage protein
Nucleic acid của phage xâm nhập vào tế bào
Protein của phage được tổng hợp, acid nucleic được nhân lên, vật chất di truyền tế bào chủ bị phá
Hình 5.1 Chu trình sinh tan của bacteriophage
Phage chỉ có thể được nhân lên chỉ khi sinh trưởng trong tế bào vi khuẩn, vì vậy làm cạn nguồn dinh dưỡng trong môi trường sinh trưởng, làm hạn chế sự nhân lên của phage và kích thước của đốm. Vì mỗi đốm là kết quả của sự nhiễm một hạt phage ban đầu, có thể đếm được số lượng các đốm riêng biệt có trên môi trường (hình 5.2).
Kiểu gene của các thể đột biến phage có thể được xác định nhờ nghiên cứu các đốm. Trong một số trường hợp, sự xuất hiện của các đốm là đầy đủ. Chẳng hạn, đột biến phage làm giảm số lượng phage thế hệ sau từ những tế bào bị nhiễm thường tạo đốm nhỏ hơn. Các đốm lớn có thể được tạo ra bởi các đột biến gây ra sự tan sớm các tế bào bị nhiễm, nên mỗi đốm đó tiếp tục nhiễm nhanh hơn. Kiểu đột biến khác của phage có
thể được xác định bởi phage có khả năng hoặc không có khả năng tạo đốm trên những chủng vi khuẩn đặc biệt.
Hình 5.2 Sự xâm nhập của phage vào tế bào vật chủ theo cả 2 dạng bố mẹ đồng thời.
r+: đốm nhỏ, r-: đốm lớn, h+: đốm mờ, h-: đốm trong
2. Tái tổ hợp di truyền trong chu kỳ sinh tan (Lytic cycle)
Các phage tuy có kích thước nhỏ bé phải nhìn dưới kính hiển vi điện tử mới thấy được. Nhưng các tính trạng của phage được quan sát dựa theo các vết tan hoặc biên độ chủ. Cho hai dòng phage T4 có kiểu gene khác nhau nhiễm vào một tế bào vi khuẩn E.coli, một vài phage thế hệ sau sẽ thực hiện tái tổ hợp di truyền, DNA phage sao chép và trao đổi đoạn nếu có nhiễu âm. Allele r- tan nhanh, kết quả tạo ra đốm lớn, allele h- nhiễm vào các tế bào chủ, kết quả tạo đốm trong. Phép lai như sau:
r-h+ r+h-
Kết quả thu được bốn kiểu đốm. Hai kiểu đốm đục, lớn và đốm trong, nhỏ tương ứng với kiểu hình của phage bố mẹ. Hai kiểu hình khác, đốm trong lớn, đốm mờ nhỏ là dạng tái tổ hợp tương ứng kiểu gene r-h- và r+h+. Khi nhiều vi khuẩn bị nhiễm số dạng tái tổ hợp thuận nghịch thường được tìm thấy trong số các phage ở thế hệ sau. Trong thí nghiệm, mỗi kiểu gene trong số bốn kiểu gene trên sinh ra kiểu hình khác nhau về dạng đốm (hình 5.2). Số lượng kiểu gene có thể xác định được bằng kiểm tra các đốm tạo thành. Tần số tái tổ hợp, được biểu diễn dưới dạng phần trăm, được xác định như sau:
Tần số tái tổ hợp =
Säúphtaägtøaeïhiåü10p0 Täøsänúpghage
3. Sự sắp xếp của các gene trong nhiễm sắc thể phage
Tần số tái tổ hợp có thể được sử dụng để xác định khoảng cách của bản đồ ở Eukaryote. Các thí nghiệm lập bản đồ cho thấy đột biến ở T4 được lập bản đồ thành 3 cụm riêng biệt. Cả ba cụm này có liên kết với một cụm khác. George Streisinger và cộng sự (1964) đã chứng minh bản đồ di truyền của phage T4 có dạng vòng tròn.

Màng
Sợi đuôi
Trao đổi nucleotide
Tổng hợp DNA, tái bản và thay đổi
Nhóm gen liên kết xác định nguồn gốc
Đĩa gốc của đuôi
Đầu, cổ, nếp gấp cổ
Đĩa gốc của đuôi
Đầu
Hình 5.3 Bản đồ di truyền của T4 với các marker
Trong mỗi phép lai, lập ba đến bốn marker di truyền lần lượt với mỗi nhóm và tiến hành qua toàn bộ genome của T4. Nhiều gene khác đã được xác định và lập bản đồ đầy đủ trên phân tử vòng tròn (hình 5.3). Những vùng ở vòng tròn bên trong là 3 cụm của marker T4 đã được xác định và lập bản đồ di truyền. Vòng ngoài có mặt của nhiều bộ marker lớn tạo thành toàn bộ vòng tròn của bản đồ di truyền. Bản đồ di truyền phage T4 cho thấy gene của phage T4 tạo cụm mở rộng theo chức năng của chúng. Chẳng hạn có cụm lớn các gene dùng cho sao chép DNA ở vị trí phần tư
bên trên phía phải và có cụm gene tổng hợp các cấu phần tạo nên đầu của phage ở phía dưới của vòng tròn.
Phân tử DNA của phage T4 là phân tử sợi đơn dạng thẳng, mỗi đầu tận cùng của DNA phage T4 được nhân lên hoặc lặp đoạn ở đầu cuối (terminal redundant). Do vậy, mỗi phân tử DNA có kích thước tăng thêm 2%. Khi DNA được sao chép trong tế bào, sự tái tổ hợp giữa các phần ở đầu tận cùng của bộ gen T4 với những trình tự tương đồng của bộ gen T4 khác, kết quả tạo ra sản phẩm DNA có kích thước lớn hơn khả năng chứa của phần đầu. Những phân tử chứa lặp đoạn được tạo thành vì sự tái tổ hợp trong bộ gen của phage T4 xảy ra thường xuyên, trung bình có khoảng 20% sự kiện tái tổ hợp xảy ra trên một nhiễm sắc thể. Khi phân tử DNA được gói vào phần đầu, nó được cắt bằng enzyme chỉ còn chứa khoảng 102% của chiều dài bộ gen phage T4, vì có chứa đoạn lặp lại của phần đầu.
4. Lập bản đồ cấu trúc tinh vi vùng rII của phage T4
Các nghiên cứu chi tiết về các đột biến rII của phage T4 làm sáng tỏ hơn về cấu trúc gene. Phage T4 ở dạng hoang dại r+ có khả năng nhiễm đồng thời hai nòi E.coli B và K. Các đột biến rII chỉ nhiễm nòi B nhưng không nhiễm nòi K. Seymour Benzer (1955) đã nhận được 2400 đột biến rII có nguồn gốc độc lập với nhau. Ông đã cho lai các đột biến với nhau và căn cứ vào sự xuất hiện các dạng tái tổ hợp hoang dại r+ mà lập bản đồ các điểm đột biến.
Mỗi đột biến có thể tái tổ hợp với các đột biến khác. Đột biến mất đoạn ngăn cản sự tái tổ hợp với hai hoặc nhiều đột biến điểm ở các vị trí khác nhau của gene. Mỗi mất đoạn làm mất một phần bộ gene của phage bao gồm cả vùng rII. Sử dụng đột biến mất đoạn là phương pháp đơn giản để lập bản đồ của hàng ngàn đột biến. Bản đồ mất đoạn (Deletion mapping) dựa trên sự có hoặc không có dạng tái tổ hợp. Trong bất kỳ phép lai nào giữa một đột biến điểm chưa biết và một đột biến mất đoạn, sự xuất hiện của dạng hoang dại cho thấy đột biến điểm nằm ngoài vùng mất đoạn. Ngược lại, nếu đột biến điểm xuất hiện trong vùng mất đoạn, không xuất hiện dạng tái tổ hợp kiểu hoang dại ở thế hệ sau.
Nhiều phép lai đã được thực hiện để lập bản đồ đột biến chi tiết gene rII. Khoảng cách từ A1 đến A6 và B được trình bày ở hình 5.4. Một đột biến đặc biệt đã được kiểm tra định vị ở vùng A4. Đột biến này không tái tổ hợp tạo dạng kiểu dại trong phép lai với các đột biến mất đoạn lớn như r1272, r1241, rJ3 và rPT1 nhưng nó có thể tái tổ hợp tạo dạng kiểu dại trong phép lai với rPB242, rA105 và r638. Các đột biến được tạo ra bởi cùng một khuôn, kết quả lai với các đột biến mất đoạn lớn sẽ được xếp






